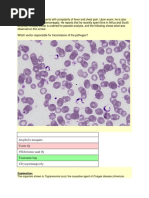

0% found this document useful (0 votes)
44 views7 pagesLec4 Trypanosoma
Uploaded by
bifusk481Copyright
© © All Rights Reserved
We take content rights seriously. If you suspect this is your content, claim it here.
Available Formats
Download as PDF, TXT or read online on Scribd
0% found this document useful (0 votes)
44 views7 pagesLec4 Trypanosoma
Uploaded by
bifusk481Copyright
© © All Rights Reserved
We take content rights seriously. If you suspect this is your content, claim it here.
Available Formats
Download as PDF, TXT or read online on Scribd
/ 7